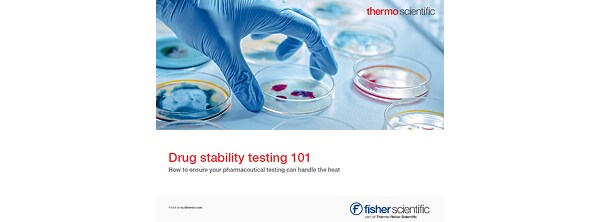
Placehoder

Cámaras climáticas Heratherm de Thermo Scientific
Control preciso, resultados excepcionales.

¿Por qué elegir las cámaras climáticas Thermo Scientific™ Heratherm™?
Soluciones aplicables



Book Your Virtual Demonstration
Get an in-depth understanding and close-up view of the Chamber's functionality with our Immersive Lab.
Our Technical Specialists and on-site film crew can live stream directly to your device and guide you through the key features.
Productos relacionados
Código del producto 6970041
Código del producto 10699640
Código del producto 10664142
Código del producto 15618540
Código del producto 7217285
Código del producto 6960052
Código del producto 10105004